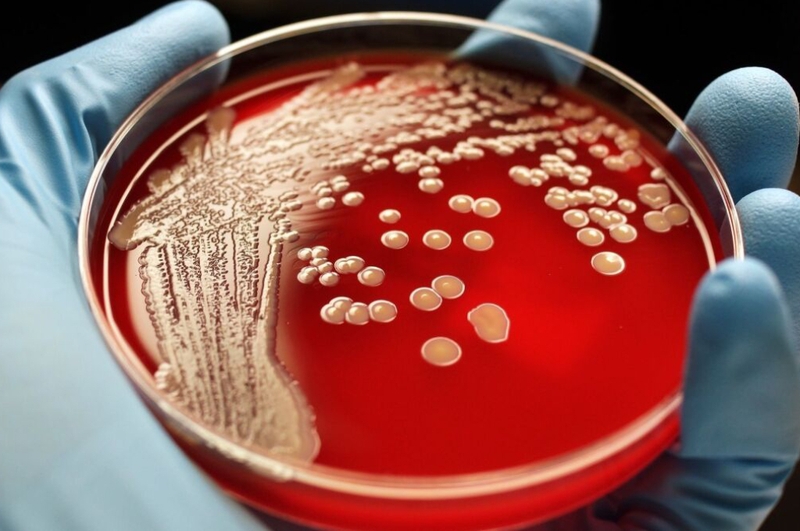
tụ cầu vàng 3

Tốt nghiệp Đại học Y Dược TP. Hồ Chí Minh. Có nhiều năm trong lĩnh vực dược phẩm. Hiện đang là giảng viên cho Dược sĩ tại Nhà thuốc Long Châu.
14/02/2025
Mặc định
Lớn hơn
Tụ cầu vàng là một loại nhiễm khuẩn còn khá lạ lẫm với đa số chúng ta. Tuy nhiên, khi nhiễm phải loại khuẩn này lại tiềm ẩn nhiều nguy cơ nguy hiểm cho sức khỏe.
Tụ cầu vàng là một trong những loại vi khuẩn có khả năng gây ra nhiều bệnh viêm nhiễm nhất trong cộng đồng. Nhưng chúng ta lại không biết rõ cách thức chúng xâm nhập vào cơ thể lúc nào. Bài viết dưới đây sẽ giúp giải đáp về vi khuẩn tụ cầu vàng cũng như các bệnh nhiễm khuẩn cho loại vi khuẩn này gây ra để phòng tránh.
Vi khuẩn tụ cầu vàng có tên khoa học là Staphylococcus aureus (MRSA), có hình dạng cầu với kích thước 0,8 - 1µm sắc tố màu vàng nhạt, xếp thành dạng đám nhỏ hình chùm nho. Loại vi khuẩn này có thể tìm thấy ở lỗ mũi và bề mặt da của 30% người khỏe mạnh mà không có tác động gì. Tuy nhiên, khi đã xâm nhập và phát triển trong cơ thể, chúng có thể gây ra các bệnh tình nặng và nguy hiểm.

Loại khuẩn này sinh ra các chất độc tố cực kỳ nguy hiểm, trong đó đáng chú ý nhất là chất Coagulase. Loại độc tố này giúp phân biệt tụ cầu vàng với các chủng tụ cầu khác. Coagulase làm cho cho máu đông lại thành các cục. Sau đó liên kết chặt chẽ với bề mặt của vi khuẩn với các cục máu đông xung quanh để bảo vệ vi khuẩn khỏi các yếu tố miễn dịch khác của cơ thể.
Đặc biệt, tụ cầu vàng còn được mệnh danh là “đương kim vô địch” về kháng kháng sinh. Chúng có thể kháng nhiều loại kháng sinh chuyên được dùng để điều trị các bệnh về nhiễm trùng tụ cầu thông thường. Do đó, khi nhiễm phải loại khuẩn này có thể gây đe dọa đến tính mạng người bệnh nếu không được điều trị đúng cách và kịp thời.
Hầu hết các trường hợp bị nhiễm tụ cầu vàng thường xảy ra với những người phải ở trong bệnh viện dài ngày, hoặc các cơ sở chăm sóc sức khỏe như viện dưỡng lão, trung tâm lọc máu,... Nhiễm khuẩn tụ cầu vàng còn do liên quan đến quá trình thực hiện các thủ thuật hoặc sử dụng các thiết bị xâm lấn như phẫu thuật, ống tiêm tĩnh mạch, thay khớp nhân tạo.
Ngoài môi trường bệnh viện, con người cũng có thể nhiễm tụ cầu vàng trong cộng đồng. Thường bắt đầu từ một chiếc nhọt trên da. Sau đó là lây lan qua đường tiếp xúc da kề da. Đối tượng dễ mắc tụ cầu vàng trong cộng đồng nhất là những người tiêm chích ma túy, có quan hệ đồng tính nam, những người sống trong môi trường chật hẹp, đông người và mất vệ sinh.
Một số yếu tố làm tăng nguy cơ nhiễm tụ cầu vàng như sau:
Khi ăn phải thực phẩm có nhiễm tụ cầu vàng sẽ sinh ra các độc tố ở ruột và gây nên tình trạng ngộ độc thực phẩm. Bệnh tình thường diễn biến cấp tính, khoảng vài giờ sau khi ăn với các triệu chứng như buồn nôn, nôn nhiều, đau quặn bụng, tiêu chảy. Loại khuẩn này thường có ở thực phẩm không được đảm bảo vệ sinh trong quá trình chế biến và bảo quản.

Mụn nhọt: Là dạng bệnh trên da phổ biến nhất do tụ cầu vàng gây nên. Vi khuẩn xâm nhập thông qua các lỗ chân lông và phát triển các túi mủ trong nang lông hoặc tuyến bã. Da ở khu vực bị nhiễm khuẩn trở nên sưng đỏ. Nhọt do tụ cầu vàng thường xuất hiện ở mông hoặc cánh tay. Nếu nhọt xuất hiện ở quanh miệng thì rất nguy hiểm vì có thể gây ra nhọt ác tính.
Viêm mô tế bào: Đây là dạng nhiễm trùng xảy ra ở lớp sâu hơn dưới da, là nguyên nhân gây sưng tấy và đỏ trên bề mặt da. Bệnh này thường xảy ra ở chân và bàn chân.
Nhiễm khuẩn tụ cầu vàng trong bệnh viện có thể gây ra các bệnh nhiễm trùng như: Nhiễm trùng vết mổ, vết bỏng, nhiễm trùng đường hô hấp.
Viêm khớp do tụ cầu vàng gây nên thường xảy ra ở đầu gối, vai, hông và ngón tay, ngón chân. Các dấu hiệu của bệnh bao gồm: Sưng và nóng tại các khớp, đau khớp dữ dội, sốt.
Trong các bệnh về do nhiễm khuẩn tụ cầu vàng gây ra, thì nhiễm khuẩn huyết và viêm nội tâm mạc là hai bệnh nặng nhất. Hai bệnh này thường có liên quan với nhau và có diễn biến lâm sàng rất phức tạp, chiếm đến 30 - 40% các trường hợp bị bệnh do nhiễm tụ cầu vàng gây ra. Đây là những bệnh cấp tính nặng và có thể gây tử vong. Nặng nhất là nhiễm khuẩn máu có khả năng gây tử vong cao do bị suy đa tạng.

Mặc dù rất hiếm gặp, nhưng hội chứng này có tính đột ngột và dễ gây nguy hiểm nhất. Hội chứng này xảy ra khi vi khuẩn tụ cầu vàng phát triển nhanh và giải phóng nhiều độc tố. Người bệnh thường có những triệu chứng như: Sốt cao, thở nhanh và nông, có thể có những cơn ngừng thở, mạch nhanh và nhỏ khó bắt, tụt huyết áp, chân tay lạnh, nôn ói, tiêu chảy, đau cơ, rối loạn ý thức, hôn mê, tiểu ít hoặc vô tiểu,...
Tụ cầu vàng là nguyên chủ yếu gây ra viêm phổi bệnh viện, bao gồm cả viêm phổi do thở máy. Bệnh viêm phổi bệnh viện không phải là bệnh xuất hiện tại thời điểm nhập viện, mà chỉ xuất hiện sau ít nhất 48 giờ nhập viện. Các triệu chứng bệnh là: Ho, sốt, đau tức ngực, khó thở, chụp X-quang có hình ảnh tổn thương phổi.
Ngoài ra, tụ cầu vàng cũng có thể gây viêm phổi trong cộng đồng nhưng tỉ lệ không nhiều, chủ yếu ở các đối tượng như: Đang bị cúm, đang dùng corticosteroid hoặc các thuốc ức chế miễn dịch, người có bệnh phế quản phổi mãn tính hoặc các bệnh hô hấp nguy cơ cao khác.
Vi khuẩn tụ cầu màu vàng có thể gây ra viêm màng não mủ, áp xe não, áp xe ngoài màng cứng, tụ mủ dưới màng cứng, viêm tắc xoang tĩnh mạch nội sọ,... Bệnh thường diễn biến trở nặng với các dấu hiệu như sốt cao, nôn ói, nhức đầu, rối loạn ý thức, mơ hồ,...
Để chẩn đoán nhiễm chủng tụ cầu vàng, các bác sĩ sẽ tiến hành các bước sau đây:
Sử dụng kháng sinh để điều trị nhiễm khuẩn tụ cầu vàng phải dựa vào mức độ nhạy cảm của chủng vi khuẩn với thuốc.
Hiện nay, các loại kháng sinh thường được sử dụng để điều trị tụ cầu vàng là: Nhóm Penicillin M và nhóm Cephalosporin thế hệ 1. Đối với chủng kháng kháng sinh methicillin (MRSA), thì kháng sinh được sử dụng là Vancomycin hoặc Linezolid.
Loại bỏ ổ nhiễm trùng bằng cách dẫn lưu ổ mủ, cắt bỏ các mô bị hoại tử, chăm sóc vết thương hở ngoài da, tháo bỏ các thiết bị y tế bị nhiễm trùng trong cơ thể,...
Những người bị nhiễm tụ cầu vàng được áp dụng các biện pháp hạn chế tiếp xúc để ngăn chặn sự lây lan của vi khuẩn. Nhân viên y tế và người nhà chăm sóc người bệnh bị cách ly có thể được yêu cầu phải mặc quần áo bảo hộ và tuân thủ quy trình vệ sinh tay nghiêm ngặt. Dụng cụ y tế phải được vô khuẩn tuyệt đối để tiêu diệt nguồn gây bệnh. Vệ sinh môi trường phòng bệnh sạch sẽ.
Rửa tay đúng cách: Rửa tay với xà phòng ít nhất 20 giây kèm theo các động tác vệ sinh toàn bộ kẽ tay, ngón tay và lòng bàn tay. Có thể mang theo một chai nước khử trùng chứa ít nhất 62% cồn để tiện rửa tay nếu không có chỗ rửa ở gần.
Giữ vết thương sạch và che kín: Các vết cắt, trầy xước được giữ sạch, băng kín bằng băng khô và vô trùng cho đến khi lành. Mủ từ các vết thương thường là nơi chứa vi khuẩn tụ cầu, nên việc che phủ vết thương sẽ giúp ngăn chặn lây lan vi khuẩn.
Không dùng chung đồ cá nhân: Không dùng chung vật dụng cá nhân như khăn mặt, khăn tắm, dao cạo râu, dao cắt móng, quần áo, đồ chơi thể thao,...
Giảm rủi ro từ băng vệ sinh dạng tampon: Băng vệ sinh tampon để lâu là nơi dễ sản sinh ra vi khuẩn tụ cầu vàng. Từ đó gây ra hội chứng sốc nhiễm độc. Vì vậy, nên thay băng vệ sinh thường xuyên, ít nhất 4 giờ/lần.

Tránh sử dụng kháng sinh bừa bãi: Để hạn chế tính kháng thuốc kháng sinh của vi khuẩn tụ cầu vàng nói riêng và vi khuẩn nói chung, không nên tự ý dùng thuốc kháng sinh để điều trị khi chưa có chỉ định của bác sĩ.
Vệ sinh cá nhân sạch sẽ: Giữ vệ sinh cá nhân bằng cách tắm rửa hàng ngày với nước sạch và và phòng, nhất là sau khi vận động ra nhiều mồ hôi. Vệ sinh răng miệng và họng bằng cách đánh răng và súc họng bằng nước muối nhạt trước khi đi ngủ và sau khi thức dậy.
Hạn chế bệnh về đường hô hấp: Nên đeo khẩu trang khi đi ra ngoài đường để tránh hít phải bụi bẩn. Điều trị các bệnh viêm đường hô hấp, nhất là bệnh hô hấp trên như viêm họng, viêm mũi, viêm amidan, bệnh xoang cần điều trị dứt điểm, không nên để thành bệnh mãn tính.
Bảo đảm an toàn khi chế biến thực phẩm: Thực phẩm chưa được nấu chín hoặc để lâu trong nhiệt độ phòng có thể bị nhiễm khuẩn tụ cầu vàng. Vì vậy, cần đảm bảo thức ăn luôn nóng trên 60 độ C hoặc nguội ở 4,4 độ C trở xuống. Bọc cẩn thận và cất trữ thức ăn trong tủ lạnh càng sớm càng tốt. Luôn rửa tay trước, trong và sau khi chế biến thực phẩm. Vệ sinh dao, thớt và mặt bàn trước và sau khi sử dụng.
Giặt sạch quần áo, ga giường: Nên giặt đồ bằng nước nóng và thuốc tẩy chứa thành phần an toàn để loại bỏ vi khuẩn. Sấy khô bằng máy sấy sẽ tốt hơn là phơi khô quần áo ngoài trời.
Từ những phân tích trên đây có thể thấy, tụ cầu vàng là loại vi khuẩn nguy hiểm mà chúng ta không nên chủ quan. Nếu như có các triệu chứng như trên, hãy lập tức đến gặp các bác sĩ để được chẩn đoán chính xác tình trạng bệnh. Bên cạnh đó, có thể tìm kiếm các sản phẩm tăng cường đề kháng để chống lại các loại vi khuẩn gây bệnh tại hệ thống Nhà thuốc Long Châu trên toàn quốc.
Thanh Hương
Nguồn tham khảo: Medlatec.vn
Dược sĩ Đại họcNguyễn Vũ Kiều Ngân
Tốt nghiệp Đại học Y Dược TP. Hồ Chí Minh. Có nhiều năm trong lĩnh vực dược phẩm. Hiện đang là giảng viên cho Dược sĩ tại Nhà thuốc Long Châu.